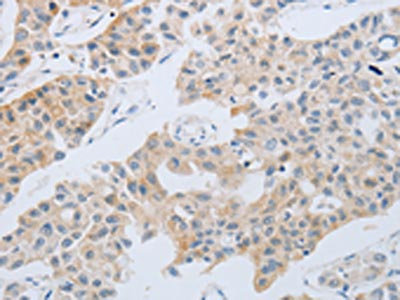

NBN Antibody
-
中文名稱:NBN兔多克隆抗體
-
貨號:CSB-PA170330
-
規格:¥1100
-
圖片:
-
The image on the left is immunohistochemistry of paraffin-embedded Human breast cancer tissue using CSB-PA170330(NBN Antibody) at dilution 1/30, on the right is treated with synthetic peptide. (Original magnification: ×200)
-
The image on the left is immunohistochemistry of paraffin-embedded Human lung cancer tissue using CSB-PA170330(NBN Antibody) at dilution 1/30, on the right is treated with synthetic peptide. (Original magnification: ×200)
-
-
其他:
產品詳情
-
Uniprot No.:
-
基因名:
-
別名:AT V1 antibody; AT V2 antibody; ATV antibody; Cell cycle regulatory protein p95 antibody; FLJ10155 antibody; MGC87362 antibody; Nbn antibody; NBN_HUMAN antibody; NBS 1 antibody; NBS antibody; NBS1 antibody; Nibrin antibody; Nijmegen breakage syndrome 1 (nibrin) antibody; Nijmegen breakage syndrome antibody; Nijmegen breakage syndrome protein 1 antibody; p95 antibody; p95 protein of the MRE11/RAD50 complex antibody
-
宿主:Rabbit
-
反應種屬:Human,Mouse,Rat
-
免疫原:Synthetic peptide of Human NBN
-
免疫原種屬:Homo sapiens (Human)
-
標記方式:Non-conjugated
-
抗體亞型:IgG
-
純化方式:Antigen affinity purification
-
濃度:It differs from different batches. Please contact us to confirm it.
-
保存緩沖液:-20°C, pH7.4 PBS, 0.05% NaN3, 40% Glycerol
-
產品提供形式:Liquid
-
應用范圍:ELISA,IHC
-
推薦稀釋比:
Application Recommended Dilution ELISA 1:2000-1:5000 IHC 1:25-1:100 -
Protocols:
-
儲存條件:Upon receipt, store at -20°C or -80°C. Avoid repeated freeze.
-
貨期:Basically, we can dispatch the products out in 1-3 working days after receiving your orders. Delivery time maybe differs from different purchasing way or location, please kindly consult your local distributors for specific delivery time.
-
用途:For Research Use Only. Not for use in diagnostic or therapeutic procedures.
相關產品
靶點詳情
-
功能:Component of the MRE11-RAD50-NBN (MRN complex) which plays a critical role in the cellular response to DNA damage and the maintenance of chromosome integrity. The complex is involved in double-strand break (DSB) repair, DNA recombination, maintenance of telomere integrity, cell cycle checkpoint control and meiosis. The complex possesses single-strand endonuclease activity and double-strand-specific 3'-5' exonuclease activity, which are provided by MRE11. RAD50 may be required to bind DNA ends and hold them in close proximity. NBN modulate the DNA damage signal sensing by recruiting PI3/PI4-kinase family members ATM, ATR, and probably DNA-PKcs to the DNA damage sites and activating their functions. It can also recruit MRE11 and RAD50 to the proximity of DSBs by an interaction with the histone H2AX. NBN also functions in telomere length maintenance by generating the 3' overhang which serves as a primer for telomerase dependent telomere elongation. NBN is a major player in the control of intra-S-phase checkpoint and there is some evidence that NBN is involved in G1 and G2 checkpoints. The roles of NBS1/MRN encompass DNA damage sensor, signal transducer, and effector, which enable cells to maintain DNA integrity and genomic stability. Forms a complex with RBBP8 to link DNA double-strand break sensing to resection. Enhances AKT1 phosphorylation possibly by association with the mTORC2 complex.
-
基因功能參考文獻:
- For rs13312986 A>G genotypes, AA was 78% in prostate cancer patients and 80% in controls. AG was 21% in patients and 20% in controls. GG was 1% in patients and none was detected in control. For rs14448 T>C genotypes, TC was 23% in patients and 20% in controls. TT was 77% in patients and 80% in controls. CC was not detected either in patients or controls. PMID: 28976141
- Expression levels of MRN complex proteins(MRE11/RAD50/NBS1) significantly predict disease-free survival in rectal cancer patients, including those treated with neoadjuvant radiotherapy, and may have value in the management of these patients. PMID: 30176843
- the present study observed a significantly higher frequency of the rs2735383 variant of the NBS1 gene, indicating that this variant may be a genetic susceptibility factor of laryngeal carcinoma. PMID: 29433451
- The CC genotype of rs2735383 did not confer an increased breast cancer risk, neither in the overall analyses nor in the subgroup analyses. PMID: 27845421
- These evidences suggest that NBS1 is regulated by two kind of mechanisms: complex formation dependent on ATM, and protein degradation mediated by an unknown MG132-resistant pathway. PMID: 28369484
- Five out of twelve patients with defects in either of MSH2, RAD50 and NBN genes suffered from rare life-threatening AE, more frequently than in control group (p = 0.0005). When all detected variants were taken into account, the majority of patients (8 out of 15) suffered from life-threatening toxicity during chemotherapy. PMID: 28376765
- To our knowledge, this is the first report of NBN gene mutation in an individual with lung cancer in the Arab world PMID: 27844240
- Low NBS1 expression is associated with low-grade epithelial ovarian cancer. PMID: 28073364
- although recruitment of the MRE11-RAD50-NBS1 (MRN) DSB-sensing complex to viral genomes and activation of the ATM kinase can promote KSHV replication, proteins involved in nonhomologous end joining (NHEJ) repair restrict amplification of viral DNA. PMID: 28855246
- Data suggest HSP90AA1-dependent regulation of ATM-NBN-CHK2 and ATR-CHK1 axes influences cells capability to repair double-stranded DNA damage; mechanisms include phosphorylation, polyubiquitination, and proteasomal degradation/proteolysis. (HSP90AA1 = heat shock protein 90kDa alpha; ATM = ataxia telangiectasia mutated protein; NBN = nibrin; CHK = checkpoint kinase; ATR = ataxia telangiectasia and Rad3 related kinase) PMID: 28631426
- Mre11-Rad50-Nbs1 complex initiates DNA double strand break repair. PMID: 28867292
- Phosphorylation status of NBS1 determines how dysfunctional telomeres are repaired. PMID: 28216226
- The results illuminate the important role of Nbs1 and CtIP in determining the substrates and consequences of human Mre11/Rad50 nuclease activities on protein-DNA lesions. PMID: 27814491
- The Nbs1 homologs that promote herpes simplex virus 1 infection also interact with the herpes simplex virus 1 ICP0 protein. PMID: 27512903
- The CC genotype of NBS1 Glu185Gln may increase lung cancer risk only for males and smokers and may serve as a practical marker for early detective and predictive purposes of lung cancer PMID: 28476809
- surmise that the higher fertility of female c.657del5 carriers reflects a lower miscarriage rate in these women, thereby reflecting the role of the NBN gene product, nibrin, in the repair of DNA double strand breaks and their processing in immune gene rearrangements, telomere maintenance, and meiotic recombination PMID: 27936167
- although Mre11 is required for efficient HR-dependent repair of ionizing-radiation-induced DSBs, Mre11 is largely dispensable for DSB resection in both chicken DT40 and human TK6 B cell lines. PMID: 27311583
- a somatic missense mutation c.1061C>T (p.P354L) in the NBN gene in a patient with CCS lacking an EWSR1-ATF1 fusion. PMID: 27109316
- The high expression of MRE11-RAD50-NBS1 complex constituents could be a predictor for poor prognosis and chemoresistance in gastric cancer PMID: 27798884
- The overall frequency of c.657del5 in unselected pancreatic ductal adenocarcinoma (PDAC) patients (5/241; 2.07%) significantly differed from that in non-cancer controls (2/915; 0.2%; P=0.006). The result indicates that the NBN c.657del5 variant represents a novel PDAC-susceptibility allele increasing PDAC risk (OR=9.7; 95% CI: 1.9 to 50.2). PMID: 27150568
- mitochondria response to low-dose radiation in radiosensitive human ataxia telangiectasia mutated (ATM)- and Nijmegen breakage syndrome (NBS)1-deficient cell lines, was investigated. PMID: 26940879
- Study shows that NBS1 may function in histone modification and in the coordination of chromatin remodeling to promote efficient and effective DNA double-strand break repair. [review] PMID: 26616756
- kinetics of the accumulation of selected DNA repair-related proteins is protein specific at locally induced DNA lesions, and that the formation of gH2AX- and NBS1-positive foci, but not 53BP1-positive NBs, is cell cycle dependent in HeLa cells PMID: 26482424
- This study found a significant trend indicating that the risk increases as the number of adverse alleles increase and significant three-locus interaction model involving NBS1 rs1805794, MRE11 rs10831234, and ATM rs227062. PMID: 26514363
- NBS1 expression exhibited an association with epithelial ovarian cancers recurrence. PMID: 26584681
- NBS1 E185Q allele carriers in renal cell carcinoma male patients had a lower 5-year survival rate. PMID: 26493193
- The heterozygous variant p.I171V in NBS1 was found at a low frequency and without clinical significance among Korean patients with high-risk breast cancer lacking BRCA1 and BRCA2 mutations. PMID: 25712764
- VRK1 regulation of NBS1 contributes to the stability of the repair complex and permits the sequential steps in DNA damage response. PMID: 26869104
- genetic variants at NBN gene may contribute to gastric cancer susceptibility. PMID: 26402912
- findings reveal a novel model for an intestinal bowel disease phenotype that occurs upon combined loss of the DNA repair cofactors ATMIN and NBS1 PMID: 26544571
- the rs2735383C/G polymorphism of NBS1 might contribute to the risk for colorectal cancer. PMID: 26186548
- These findings indicate the importance of the acetylation-dependent dynamic binding of NBS1 to damaged chromatin, created by histone H2AX exchange, for the proper accumulation of NBS1 at DNA damage sites. PMID: 26438602
- NBS1 has multifunctional roles in response to DNA damage from a variety of genotoxic agents, including IR PMID: 26308066
- Co-expression of HIF-1a and NBS1 in primary tumors of patients with lung adenocarcinoma correlates with a worse prognosis PMID: 25959252
- Furthermore, they collectively help to explain how MRN regulates DNA repair pathway choice. [review] PMID: 25576492
- Mutations within the NBN gene are responsible for the Nijmegen breakage syndrome. PMID: 25485873
- NBN(p70) expressing cells undergo a degree of stress-induced replicative senescence via p38/MK2 activation. PMID: 25214013
- In vitro studies correlated NBN gene overexpression with PCa cells radioresistance. PMID: 25415046
- This work demonstrates that the Mre11-Rad50-Nbs1 DNA repair complex positively regulates AAV replication and plays a role in the integration of adeno-associated airus in the presence of herpes simplex virus 1. PMID: 25903339
- ATP switches the Mre11-Rad50-Nbs1 repair factor between signaling and processing of DNA ends. (Review) PMID: 25213441
- Data provide compelling evidence that BMI1 decreases etoposide-induced G2/M checkpoint activation via reducing NBS1-mediated ATM activation. PMID: 25088203
- our results suggest that ERCC1 rs11615, ERCC2 rs1799793, and NBN rs1805794 polymorphisms in the DNA repair pathways may influence the response to chemotherapy and OS of gastric cancer. PMID: 25542228
- The rs1805794G>C of NBS1 may be a functional genetic biomarker for lung cancer.[meta-analysis] PMID: 25771871
- our results did not confirm the hypothesis of a possible role of NBN and XRCC3 SNPs in acute lymphoblastic leukaemia risk. PMID: 25176580
- Expression of the forkhead-associated domain-mutated NBS1 rendered the exponentially growing cell population slightly (but significantly) more sensitive to ionizing radiation. PMID: 24614819
- findings identify TCOF1 as a DDR factor that could cooperate with ATM and NBS1 to suppress inappropriate rDNA transcription and maintain genomic integrity after DNA damage. PMID: 25512513
- NBS1 Glu185Gln polymorphism is associated with increased risk for urinary system cancer. PMID: 25073514
- These data establish that MRE11A, RAD50, and NBN are intermediate-risk breast cancer susceptibility genes. PMID: 24894818
- These results articulate a model of inhibition of adeno-associated virus gene expression in which physical interaction of viral DNA with Mre11/Rad50/Nbs1 complex is more important than enzymatic activity. PMID: 25320294
- The results suggest that DNMT1 function in the regulatory response is controlled by NBS1. PMID: 23918933
顯示更多
收起更多
-
相關疾病:Nijmegen breakage syndrome (NBS); Breast cancer (BC); Aplastic anemia (AA)
-
亞細胞定位:Nucleus. Nucleus, PML body. Chromosome, telomere. Chromosome.
-
組織特異性:Ubiquitous. Expressed at high levels in testis.
-
數據庫鏈接:
Most popular with customers
-
-
YWHAB Recombinant Monoclonal Antibody
Applications: ELISA, WB, IHC, IF, FC
Species Reactivity: Human, Mouse, Rat
-
Phospho-YAP1 (S127) Recombinant Monoclonal Antibody
Applications: ELISA, WB, IHC
Species Reactivity: Human
-
-
-
-
-